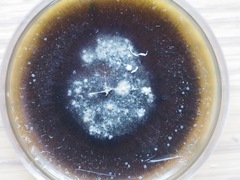
Hypoxylon hypomiltum
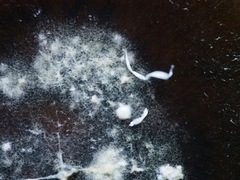
Hypoxylon hypomiltum

Hypoxylon hypomiltum: taxon details and analytics
- Domain
- Kingdom
- Fungi
- Phylum
- Ascomycota
- Class
- Sordariomycetes
- Order
- Xylariales
- Family
- Hypoxylaceae
- Genus
- Hypoxylon
- Species
- Hypoxylon hypomiltum
- Scientific Name
- Hypoxylon hypomiltum
Summary description from Wikipedia:
Hypoxylon hypomiltum
Hypoxylon hypomiltum är en svampart. Hypoxylon hypomiltum ingår i släktet Hypoxylon och familjen kolkärnsvampar.
...Images from inaturalist.org observations:
We recommend you sign up for this excellent, free service.
Parent Taxon
Sibling Taxa
- Acrostaphylus pulvereus
- Hypoxylon aeruginosum
- Hypoxylon albolanatum
- Hypoxylon anthochroum
- Hypoxylon aucklandiae
- Hypoxylon carneum
- Hypoxylon cercidicola
- Hypoxylon chathamense
- Hypoxylon cinnabarinum
- Hypoxylon conostomum
- Hypoxylon crocopeplum
- Hypoxylon cyanescens
- Hypoxylon diatrypeoides
- Hypoxylon dieckmannii
- Hypoxylon dingleyae
- Hypoxylon duranii
- Hypoxylon erythrostroma
- Hypoxylon eurasiaticum
- Hypoxylon fendleri
- Hypoxylon ferrugineum
- Hypoxylon fragiforme
- Hypoxylon fraxinophilum
- Hypoxylon fuscoides
- Hypoxylon fuscopurpureum
- Hypoxylon fuscum
- Hypoxylon glycyrrhiza
- Hypoxylon haematostroma
- Hypoxylon howeanum
- Hypoxylon hughesii
- Hypoxylon hypomiltum
- Hypoxylon investiens
- Hypoxylon jecorinum
- Hypoxylon julianii
- Hypoxylon julii
- Hypoxylon lenormandii
- Hypoxylon lividipigmentum
- Hypoxylon macrocarpum
- Hypoxylon medullare
- Hypoxylon morganii
- Hypoxylon mulleri
- Hypoxylon mutans
- Hypoxylon notatum
- Hypoxylon nothofagicola
- Hypoxylon novemexicanum
- Hypoxylon ochraceum
- Hypoxylon olivaceopigmentum
- Hypoxylon olivicolor
- Hypoxylon olliforme
- Hypoxylon papillatum
- Hypoxylon perforatum
- Hypoxylon petriniae
- Hypoxylon porphyreum
- Hypoxylon pseudofuscum
- Hypoxylon rickii
- Hypoxylon rubiginosum
- Hypoxylon rutilum
- Hypoxylon samuelsii
- Hypoxylon sclerophaeum
- Hypoxylon semimultiforme
- Hypoxylon shearii
- Hypoxylon subcorticeum
- Hypoxylon subcrocopeplum
- Hypoxylon subgilvum
- Hypoxylon subrutiloides
- Hypoxylon subrutilum
- Hypoxylon subticinense
- Hypoxylon sulcatum
- Hypoxylon texcalense
- Hypoxylon texense
- Hypoxylon ticinense
- Hypoxylon torrendii
- Hypoxylon trugodes
- Hypoxylon vogesiacum
- Nodulisporium atroviride
- Nodulisporium cecidiogenes
- Nodulisporium gregarium
- Nodulisporium tabacinum
- Nodulisporium umbrinum